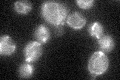
YPL104W
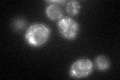
YPL104W

View description
Mitochondrial aspartyl-tRNA synthetase, required for acylation of aspartyl-tRNA; yeast and bacterial aspartyl-, asparaginyl-, and lysyl-tRNA synthetases contain regions with high sequence similarity, suggesting a common ancestral gene
Localization:
Intensity:
Fold change:
Significance:
-
C’ GFP library in SD
mitochondria24.71 -
N' NOP1pr-GFP in SD

mitochondria40.697 -
N' TEF2pr-mCherry in SD

missing0 -
N' NATIVEpr-GFP in SD

below threshold21.3215 -
N' TEF2pr-VC and Cyto-VN in SD

#N/A0 -
C’ GFP library in SD+DTT
mitochondria27.991.13No -
C’ GFP library in SD+H2O2

mitochondria25.521.03No -
C’ GFP library in Starvation Media

mitochondria23.380.94No -
C’ GFP library on the background of Pup2-DaMP

mitochondria -
C’ GFP library on the background of CCT mutant

mitochondria29.30491.18567No
